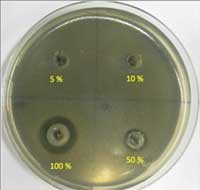

Supporting materials
Pracovní listy 1-3 (spojený dokument Word)
Download
Download this article as a PDF

Preložila Zdena Tejkalová. Téma polymery je často omezeno na hodiny chemie. Projekt Establish nabízí některé praktické aktivity ke zkoumání těchto materiálů a některých z jejich lékařských aplikací.

Polymery používáme každý den, například ve formě plastů, nátěrů a papíru a také v produktech jako jsou plenky či šampóny. Polymery jsou tvořeny velkými molekulami, vytvořenými z opakujících se strukturních jednotek.
Následující aktivity byly vytvořeny, aby studentům pomohly propojit makroskopický svět materiálů, které můžeme vidět s mikroskopickým světem částic (atomů a molekul), které vidět nemůžeme, to vše s využitím reálných aplikací. Využívají učení založené na dotazech, kdy studenti jsou povzbuzováni, aby rozvíjeli své myšlenky na základě pozorování praktických činností a poté je vyzkoušeli v nových souvislostech.

V první aktivitě, studenti ve věku 13-15 zkoumají difúzi kapalin různými typy polymerních membrán (Pracovní list 1). Potom uvažují o využití membrán v medicíně: jak fungují lidské ledviny a jak může dialyzační přístroj převzít jejich funkce (Pracovní list 2). Zvláštní důraz je kladen na porozumění tomu, proč jsou některé molekuly během dialýzy z těla odstraněny a některé ne. Studenti by také mohli předpovídat, co by se stalo, kdyby dialyzační kapalinou byla voda, což jim umožní porozumět osmóze.
Ve druhé aktivitě studenti ve věku 15-17 vytvoří membrány z polyvinylchloridu (PVC) a zkoumají jejich fyzikální i chemické vlastnosti. Potom vyrobí a otestují antibakteriální PVC membránu (Pracovní list 3). Jako rozšíření této aktivity, studenti mohou zkoumat membrány z různých změkčovadel nebo zkoumat antibakteriální účinnost membrán, obsahujících různé kovy nebo různá množství kovů.
Všechny tři pracovní listy lze stáhnout ve Wordu nebo PDF z webových stránek Science in Schoolw8.
V této aktivitě by se studenti měli zamyslet nad neviditelným světem atomů a molekul a s pomocí této aktivity, dojdou k pochopení částicové povahy hmoty. Tyto aktivity mohou být využity k dokázání existence molekul a také toho, že molekuly mohou mít různou velikost. Studenti budou zkoumat difuzi částic různými typy membrán, poté budou moci své poznatky aplikovat při úvahách o ledvinách a dialýzew1.

Studenti se již setkali s použitím sít k rozdělení směsí a s nutností použít síta s vhodně velkými otvory. K základnímu seznámení s plastovými membránami, vyučující může využít srovnání s balením potravin, studenti sami mohou potom zkoumat různé membrány. Vyučující by měl v diskuzi navrhnout možná vysvětlení získaných výsledků. Pokud je třeba, pomáhá rozvíjet myšlenku, že existují částice různých velikostí a membrány s rozdílně velkými otvory.
Myšlenkou byla využít škálu folií/membrán např. levné plastové sáčky, obaly od potravin či potravinové tašky ke zkoumání prostupu částic jódu různými membránami. Studenti by měli provést několik experimentů, jak je navrženo v Tabulce 1. Vyučující by je měl vyzkoušet předem, aby se ujistil, že dávají dostatečně odlišné výsledky.
|
Trubice číslo |
Membrána |
|---|---|
| 1 |
Bez membrány |
| 2 |
Jam-pot cover |
| 3 |
Plastový sáček nebo igelitová folie |
| 4 |
Latexová rukavice |
Studenti by se měli naučit:
Zkoumejte pohyb částic jódu různými typy membrán. Z každé membrány si vytvořte malý sáček a umístěte ho do trubice se škrobovým roztokem, jak je vidět na Obrázku 1. Do každého sáčku nalijte trochu roztoku jódu a pozorujte, co se stane.

| 1 | 2 | 3 | 4 | ||
|---|---|---|---|---|---|
|
Barva na začátku |
V malém sáčku |
||||
|
V trubici |
|||||
|
Barva na konci |
V malém sáčku |
||||
|
V trubici |


| 1 | 2 | 3 | 4 | ||
|---|---|---|---|---|---|
|
Barva na začátku |
V malém sáčku |
||||
|
V trubici |
|||||
|
Barva na konci |
V malém sáčku |
||||
|
V trubici |
Lidská ledvina je úžasný organ s dvěma základními funkcemi: údržba vodní rovnováhy v těle a vylučování močoviny, solí a vody. Každý den ledviny přefiltrují z krve 180 l kapaliny – většina je reabsorbována společně s živinami, které tělo potřebuje, jako např. glukóza a aminokyseliny. Ze 180 l přefiltrované kapaliny, ledviny produkují zhruba 2 l moči, která obsahuje odpadní produkty, např. pro tělo toxickou močovinu. Moč se před vyloučením hromadí v močovém měchýři.

a) Pohled na ledvinu. Filtrace probíhá ve 3 milionech nefronů, kam se natlakovaná krev dostává z kapilár.
Obrázok so súhlasom Piotr Michał Jaworski; zdroj obrázku: Wikimedia Commonsb) Detail struktury nefronu. Malé molekuly a vody jsou filtrovány z krve otvory ve stěně Bowmanova váčku. V dalších částech nefronu jsou reabsorbovány molekuly, které tělo potřebuje
Obrázok so súhlasom http://osmoregulation-apbio3.wikispaces.com
Při selhání ledvin následuje smrt přibližně za čtyři dny, protože močovina se hromadí a tělo ztrácí kontrolu nad vodní rovnováhou. Lidský život lze zachránit pomocí dialýzy, což obvykle znamená návštěvu nemocnice třikrát týdně. Během dialýzy, což přibližně trvá šest až osm hodin, krev z pacientova těla odtéká trubicí do přístroje, kde prochází podél filtru, nazývaného dialyzační membrána. Na druhé straně membrány protéká speciální dialyzační roztok. Složení tohoto roztoku zajišťuje vylučování močoviny z krve, ale glukóza ani aminokyseliny membránou neprojdou. Krev – bez močoviny- se potom vrací do těla.
Během této aktivity student vyrobí membrány z PVC a budou zkoumat vliv změkčovadla na fyzikální a chemické vlastnosti membrány (tyto membrány mohou být také využity v první aktivitě). Potom si vyrobí membránu z PVC obsahující stříbrné částice a její inkubací přes noc otestují antibakteriální vlastnosti.
Jako další stupeň zkoumání by studenti mohli lépe pochopit antimikrobiální vlastnosti membrány zabudováváním různých koncentrací stříbrných částic do membrán a zjišťování vlivu koncentrace na inhibovaná místa, která pozorují. Typické příklady jsou ukázány vpravo.
Nepatogenní Escherichia coli může být získána z American Tissue Culture Collection (ATCC)w2. BAA 1427 je nepatogenní náhradní kmen vhodný pro použití v tomto experimentu.
Polymer polyvinylchlorid (PVC) je levný a odolný plast, využívaný na potrubí, cedule a oblečení. Pro zvýšení pružnosti a snadnější manipulaci jsou do něj často přidávána změkčovadla. V této úloze vytvoříte PVC membránu se změkčovadlem i bez něj a potom porovnáte jejich fyzikální a chemické vlastnosti.
Antimikrobiální membrány jsou využívány v mnoha medicinálních technologiích a jsou vyráběny zabudováváním nanočástic nebo mikročástic stříbra či dalších kovů do polymerů. V přítomnosti kyslíku (na vzduchu) a vody elementární stříbrné částice reagují za vzniku stříbrných iontů (Ag2+), které mohou rozbít buněčnou stěnu, inhibovat buněčnou reprodukci a narušit metabolismus některých bakterií, virů, řas a hubw3, w4.
Bezpečnostní poznámka: Vše by mělo probíhat v digestoři. Tetrahydrofuran je vysoce hořlavá kapalina, která může způsobit vážné podráždění očí. Zacházejte s ní opatrně, pouze v digestoři a v rukavicích.
Vytvořte čtyři membrány opakováním postupu seshora, každou s rozdílným množstvím změkčovadla, přidaného do zahřívaného rozpouštědla (viz Tabulka 4).
|
Vzorek číslo |
PVC (g) |
Rozpouštědlo (ml) |
Dibutyl-sebakát (ml) |
|---|---|---|---|
| 1 | 1.5 | 20 | 0.5 |
| 2 | 1.5 | 20 | 1 |
| 3 | 1.5 | 20 | 2 |
| 4 | 1.5 | 20 | 3 |


Výroba antibakteriálního PVC, obsahujícího stříbrné částice, vyžaduje membránu s velkými mezerami, což je důvod proč použijeme změkčovadlo. Stříbro je přidáno ve formě dusičnanu stříbrného, který je pak redukován citronanem sodným.
Nyní můžete zkoumat antibakteriální vlastnosti vyrobených membrán.
Bezpečnostní poznámka: Jako u všech mikrobiálních studií, celou dobu by mělo být používáno sterilizované náčiní (buď sterilizováno v autoklávu nebo tlakovém hrnci, nebo namočené v etanolu a pak vyžíhané). To zahrnuje i nůžky, kterými střiháte membránu. Abyste zabránili křížové kontaminaci, omyjte očkovací smyčku před použitím antibakteriálním prostředkem.
Antibakteriální vlastnosti těchto membrán je činí užitečnými při ošetřování ran a popálenin, včetně infekcí bakteriemi jako například methicilin-rezistentní Staphylococcus aureus (MRSA) či E. coli.
Tyto aktivity jsou mezi těmi vyučovacími aktivitami, rozvíjenými projektem Establish, EU financovaným projektem na podporu šíření povědomí a používání badatelské metody ve výuce přírodních věd pro studenty základních a středních škol (ve věku 12-18 let). Skupina více než 60 partnerů z 11 evropských zemí pracuje společně na rozvoji a adaptaci učebních aktivit ve třídách napříč celou Evropou.
Aktivity v tomto článku jsou převzaty z platformy věnované vyučování nazvané “Objevování mezer”. V době, kdy šel tento článek do tisku, byly k dispozici také materiály o zvuku a invaliditě, dále jsou plánována témata věnovaná kosmetice, chitosanu, forenzním vědám, fotochemii, obnovitelným zdrojům energie a zobrazovacím metodám v medicíně. Pro vice informací a pro stažení kompletních jednotek navštivte stránky projektu Establishw5.

Velmi důležité je využívání nanočástic ve zdravotnické péči. Pochopení dopadu nanočástic na buňky a tkáně je zásadní pro bezpečnost, spolehlivou diagnózu a léčbu chorob. Mnoho medicínských nanočástic je založeno na kovech a rentgenové paprsky Evropského synchrotronového radiačního přístroje (ESRF)w6 se hodí pro sledování například interakce jednotlivých nanočástic se zmrazenými buňkami v nanoměřítku (Lewis et al., 2010).
ESRF je člen EIROforumw7, vydavatele Science in School.
Aktivity popsané v tomto článku jsou založené na informacích z Wilms et al. (2004; Pracovní list 1), od Alison Graham z Dublin City University, Irsko (Pracovní list 2), a od Laura Barron a James Chapman z Dublin City University (Pracovní list 3).
Pracovní list 1, Pracovní list 2 a Pracovní list 3 (oddělená PDF)
Pracovní listy 1-3 (spojený dokument Word)
Zajímali jste se někdy o to, jak funguje dialýza? Jak lze plasty využít k filtraci nežádoucích látek z vašeho těla? A co antibakteriální plasty? Tento článek představuje roli polymerů v dialyzačních přístrojích využívaných k filtraci krve a k ošetření ran.
Experimenty pro mladší studenty, popsané v tomto článku, jim pomohou porozumět polymerům a jejich využití při dialýze. V aktivitách pro starší studenty, třída si vyrobí své vlastní PVC – jeden z nejběžnějších polymerů dneška – a bude zkoumat jejich antibakteriální vlastnosti.
Aktivity jsou vhodné do hodin chemie i biologie, zaměřené na polymeraci, osmózu, difúzi a exkreci. Mohly by být následovány diskuzí o širším využití polymerů, selektivně propustných membránách nebo o exkreci.
Andrew Galea, Giovanni Curmi Post-Secondary School Naxxar, Malta
Pracovní listy 1-3 (spojený dokument Word)
Download this article as a PDF